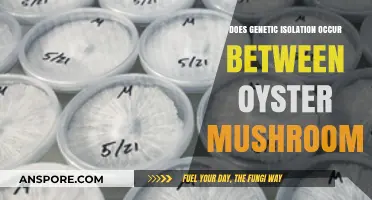
Genetic Isolation in Oyster Mushrooms: What's the Deal?

Mushrooms are a great source of dietary fiber, protein, vitamins, and minerals. However, the way you cook mushrooms can significantly impact their nutritional content. Frying mushrooms can result in a loss of protein and antioxidants, while also increasing their fat content. On the other hand, grilling and microwaving mushrooms have been found to preserve most of their nutritional value, with increased antioxidant levels and minimal loss of nutrients. Therefore, when it comes to preparing mushrooms in a way that retains their health benefits, grilling and microwaving are recommended over frying.
| Characteristics | Values |
|---|---|
| Loss of vitamins | Boiling mushrooms results in a loss of vitamins |
| Loss of protein | Frying mushrooms results in a loss of protein |
| Increased fat content | Frying mushrooms increases the fat content |
| Best cooking methods | Grilling and microwaving are the best methods to preserve the nutritional profile of mushrooms |
| Increased antioxidant levels | Grilling and microwaving mushrooms increases their antioxidant levels |
| Olive oil | Grilling mushrooms with olive oil enhances the fatty acid profile without increasing the calorie content |
Explore related products
What You'll Learn

Frying mushrooms increases fat content
Mushrooms are a great source of dietary fibre, protein, vitamins, and minerals. However, the way you cook them can significantly impact their nutritional profile.
Frying mushrooms can lead to a loss of protein and antioxidants. This is due to the leaching of soluble substances into the oil, which can also cause a spike in the fat content of the mushrooms. Therefore, frying mushrooms increases the overall fat content of the dish.
A study by scientists from the Mushroom Technological Research Center in La Rioja, Spain, compared the nutritional profiles of four popular types of mushrooms: white button, shiitake, oyster, and king oyster. They found that frying mushrooms resulted in a significant loss of protein and antioxidants compared to other cooking methods like grilling and microwaving.
Grilling and microwaving mushrooms are considered the best methods to preserve their nutritional content. These cooking techniques result in minimal nutrient loss and can even increase the levels of certain antioxidants. Additionally, grilling mushrooms with a small amount of olive oil can enhance the fatty acid profile without significantly increasing the calorie content.
Overall, while frying mushrooms can make them more palatable to some, it is important to be aware of the potential impact on their nutritional value, especially the increase in fat content.
The Surprising Age of Oh Shiitake Mushrooms
You may want to see also

Grilling mushrooms is a healthier alternative
Mushrooms are a healthy food choice, rich in dietary fibre, vitamins (B1, B2, B12, C, D, and E), and minerals such as zinc or selenium. They are also low in calories and fat. However, the cooking process can affect the nutritional profile of mushrooms. Frying mushrooms leads to a severe loss of protein and antioxidants and increases the fat content. Boiling mushrooms is also not recommended as it leads to a decrease in nutritional values.
Additionally, grilling mushrooms can enhance their flavour and make them more palatable. A little olive oil can be added during grilling to enhance the fatty acid profile without significantly increasing the calorie content.
In conclusion, grilling mushrooms is a healthier alternative to frying or boiling as it preserves their nutritional properties, including their antioxidant capacity, and can also improve their flavour. So, the next time you add mushrooms to your meal, consider grilling them to retain their health benefits and flavour.
Mushroom Stock: A Savory, Umami-Rich Broth
You may want to see also

Microwaving preserves nutritional value
Frying mushrooms is a popular cooking method, but it can lead to a significant loss of nutrients. Mushrooms are rich in fiber, vitamins, protein, and antioxidants. However, frying them can result in a decrease in their nutritional value.
When mushrooms are fried, they can lose essential proteins and antioxidants due to the leaching of soluble substances into the oil or water. This process can also increase the fat content of the mushrooms, making them less healthy. Therefore, frying is not the best method to preserve the nutritional content of mushrooms.
On the other hand, microwaving mushrooms has been found to be a superior cooking method for retaining their nutritional value. A study by scientists from the Mushroom Technological Research Center in La Rioja, Spain, compared the nutritional profiles of various mushrooms before and after cooking using different methods, including frying and microwaving. The results showed that microwaving mushrooms led to minimal loss of nutrients and even increased their antioxidant levels.
Microwaving is a convenient and quick way to cook mushrooms, and it does not significantly break down their nutrients. This is because microwaves cook food rapidly and with less water, preserving heat-sensitive nutrients like Vitamin C. Additionally, the World Health Organization has stated that microwave ovens are safe and do not diminish the nutritional value of food when used according to the manufacturer's instructions.
In conclusion, microwaving mushrooms is a healthier alternative to frying. It helps retain their nutritional content, especially antioxidants, and does not increase the fat content. Therefore, microwaving is a recommended cooking method for those who want to preserve the nutritional value of mushrooms.
Mushroom Toxicity in Horses: What You Need to Know
You may want to see also
Explore related products

Boiling mushrooms reduces nutritional value
Mushrooms are a great source of nutrition, offering fibre, vitamins, protein, carbohydrates, and minerals. However, the method of preparation can significantly impact their nutritional value.
Boiling mushrooms is one of the least effective ways to retain their nutritional value. A study published in the International Journal of Food Sciences and Nutrition found that boiling mushrooms led to a loss of vitamins and proteins. Specifically, the study showed that boiling resulted in the leaching out of soluble substances, such as nitrogenous substances, leading to a decrease in the nutritional value of the mushrooms.
Another study, focusing on the effects of cooking and preservation on the nutritional composition of mushrooms, found that boiling resulted in the greatest loss of total phenolic content compared to other cooking methods. This loss was attributed to the leaching out and denaturation of polyphenols during the boiling process.
Additionally, boiling mushrooms can also increase their carbohydrate content while decreasing their lipid content.
Therefore, if you're looking to retain the nutritional value of mushrooms, boiling is not the ideal cooking method. Instead, grilling and microwaving are recommended as they preserve most of the nutrients and even increase the antioxidant levels in mushrooms.
The Ultimate Guide to Crushing Mushrooms
You may want to see also

Drying mushrooms increases protein content
Mushrooms are a great source of dietary fibre, vitamins, protein, and minerals. They are also low in fat and calories, making them a healthy addition to any meal. However, the way you cook mushrooms can significantly impact their nutritional value.
Frying mushrooms, for example, leads to a loss of protein and antioxidants and increases their fat content. This is likely due to the leaching of soluble substances into the oil. Boiling mushrooms is also a poor choice, as it results in a loss of vitamins and antioxidants.
So, does that mean you should avoid cooking mushrooms altogether? Not necessarily—it depends on the cooking method. Grilling and microwaving mushrooms, for instance, are recommended as these techniques preserve most of the nutrients and even increase antioxidant levels.
Now, when it comes to drying mushrooms, the process can indeed increase their protein content. In one study, drying fresh mushrooms resulted in a significant increase in protein content from 2.01% to 24.36%. This increase in protein content is likely due to the removal of water, which concentrates the remaining nutrients. Additionally, drying mushrooms can also increase their carbohydrate and phenolic content.
It is worth noting that the drying temperature can impact the nutritional profile of mushrooms. For instance, a higher drying temperature of 70°C can result in greater losses of total phenolic compounds, phenolic acids, organic acids, and ergosterol content compared to a lower temperature of 40°C. Therefore, when drying mushrooms to increase their protein content, it is essential to consider the drying temperature to optimize their nutritional value.
Freezing Mushrooms: A Step-by-Step Guide to Freeze Drying
You may want to see also
Frequently asked questions
Yes, frying mushrooms results in a loss of protein and antioxidants, and increases the fat content.
Grilling and microwaving mushrooms are considered the best ways to preserve the nutritional profile of mushrooms.
Mushrooms are rich in fiber, vitamins (B1, B2, B12, C, D, and E), protein, and trace minerals such as zinc or selenium.
Yes, boiling mushrooms leads to a decrease in nutritional value, specifically vitamins and antioxidants.
Yes, preservation methods such as drying and freezing can also impact the nutrient content of mushrooms. Drying was shown to increase protein and carbohydrate content, while freezing had minimal impact on the nutrient profile.